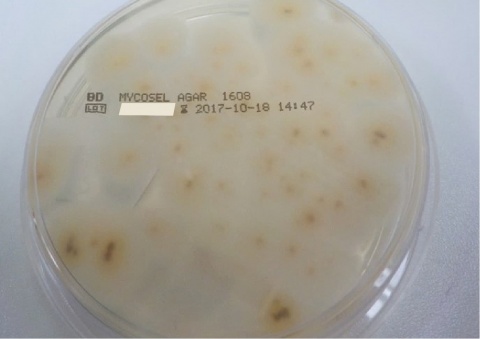

Bundeswehrzentralkrankenhaus Koblenz
Einleitung
Die Tinea ist eine durch Dermatophyten (Fadenpilze) hervorgerufene Infektion des Stratum corneum der Epidermis, der Nägel und/oder Haare, die durch Invasion und Abbau des keratinhaltigen Gewebes gekennzeichnet ist. Klinisch präsentiert sich die Manifestation an der Haut durch entzündliche erythematöse, leicht schuppende randbetonte Plaques mit zentraler Abblassung und zentrifugaler Ausdehnung. Neben geophilen und anthropophilen Arten sind es vor allem zoophile Dermatophyten, welche eine oftmals deutlich stärkere Entzündungsreaktion hervorrufen, die häufig die Notwendigkeit einer systemischen antimykotischen Therapie erfordert.
Im dargestellten Fall konnte der kulturelle Nachweis einer Infektion mit Trichophyton erinacei erbracht werden. Träger dieses Hautpilzes sind vor allem Igel; die Übertragung auf den Menschen und damit verbundene humane Infektionen sind jedoch selten.
Fallbeschreibung
Anamnese
In unserer Abteilung stellte sich eine 22-jährige Patientin mit der Einweisung eines niedergelassenen Dermatologen zum Ausschluss einer linearen IgA-Dermatose vor. Seit neun Wochen bestand ein progredienter Hautausschlag mit starkem Juckreiz, welcher sich ausgehend vom Oberbauch auf den -Rücken sowie die oberen und unteren Extremitäten ausgebreitet hatte. Ambulant erfolgte bereits eine topische Therapie mit kortikoidhaltigen Externa, welche jedoch zu keiner Befundverbesserung geführt hatte.
An Vorerkrankungen gab die Patientin ein Kraniopharyngeom mit Chiasma-Kompression an. Des Weiteren besitze sie neben einer Katze auch zwei Igel als Haustiere, davon einen erst seit einem Monat; Allergien seien nicht bekannt.
Hautbefund
Am Oberbauch linksseitig zeigt sich eine handflächengroße erythematöse Plaque, teilweise mit pustulösen Aspekt, mit zentraler Abblassung und ausgeprägtem krustösen Randwall (Abbildung 1). An den Armen streckseitig, an den Oberschenkeln sowie an den Schultern fanden sich teils gruppiert stehende, teils exkoriierte, stark juckende ekzematoide Hautveränderungen.
Histopathologischer Befund
Teils bullöse und pustulöse, teils superfizielle, vorwiegend perivaskuläre, geringe interstitielle Dermatitis mit Besiedlung durch kokkoide Bakterien.
Klinische Interpretation: Die Befundkonstellation spricht für das Vorliegen einer Impetigo bullosa, das typische Bild einer linearen IgA-Dermatose stellt sich, auch immunhistochemisch, nicht dar; kein Anhalt für Malignität.
Mykologischer Befund
- nativ positiver Pilznachweis
- auf Mycosel Agar kultureller Nachweis von Trichophyton erinacei (Abbildung 2)
Therapie und Verlauf
Dermatologie und Venerologie, BwZKrhs Koblenz)
Die stationäre Aufnahme der Patientin erfolgte zur erweiterten Diagnostik und Ausschluss einer linearen IgA-Dermatose sowie zur intensivierten Therapie bei Verdacht auf Tinea corporis.
Wir führten zunächst eine Lokaltherapie mit Betamethasondipropionat/Clotrimazol-Creme (2 x tgl.) bei ausgeprägter ekzematöser Komponente durch. Unter dieser Therapie kam es lediglich zu einer geringgradigen Besserung des Hautbefundes. In der histopathologischen Begutachung eines bei Aufnahme entnommenen Hautbioptates zeigte sich das Bild einer Impetigo bullosa. Die Lokaltherapie wurde daher kurzfristig auf Betamethasonvalerat/Fusidinsäure-Creme (2 x tgl.) umgestellt. Hier-unter kam es ebenfalls zu keiner wesentlichen Befundverbesserung.
Im Rahmen der mykologischen Diagnostik konnten im Verlauf aus dem entnommenen Material der Hautveränderungen nativ Pilzbestandteile nachgewiesen werden. Wir leiteten daraufhin eine systemische antimykotische Therapie mit Terbinafin 250 mg (1 x tgl.) sowie eine topische Therapie mit Ciclopiroxcreme (2 x tgl.) ein. Unter dieser Behandlung sowie begleitender antihistaminerger Therapie mit Desloratadin 5 mg (1 x tgl.) kam es zu einer langsamen Besserung des Hautbefundes und des Juckreizes.
In der angelegten Pilzkultur zeigte sich nach vier Wochen ein Wachstum von Trichophyton erinacei. Somit ist in Zusammenschau von Anamnese und mykologischen Befunden von einer zoophilen Tinea corporis, bedingt durch die gehaltenen Igel, auszugehen. Die ekzematoiden Hautveränderungen wurden dabei als Mykid gewertet.
Fazit für die Praxis
- Trichophyton erinacei ist der am häufigsten vorkommende Dermatophyt in Igeln.
- Humane Infektionen durch Tr. Erinacei sind selten.
- Die Zunahme exotischer Haustiere begünstigt das Auftreten dieser Zoonose.
- Neben einer topischen Therapie ist bei dieser Infektion oft eine systemische Behandlung mit Terbinafin oder Azolen indiziert.
Literatur
- Hsieh CW, Sun PL, Wu YH: Trichophyton erinacei Infection from a Hedgehog: A Case Report from Taiwan. Mycopathologia 2010; 170: 417.
- Lee DW, Yang JH, Choi SJ et al.: An Unusual Clinical Presentation of Tinea Faciei Caused by Trichophyton mentagrophytes var. erinacei. Pediatric Dermatology 2011; 28: 210 – 212.
- Concha M, Nicklas C, Balcells E, Guzmán A M, Poggi H, León E, Fich F: The first case of tinea faciei caused by Trichophyton mentagrophytes var. erinacei isolated in Chile. International Journal of Dermatology 2012; 51: 283 – 285.
- Drira I, Neji S, Hadrich I, Sellami H, Makni F, Ayadi A: Tinea manuum due to Trichophyton erinacei from Tunisia, Journal de Mycologie Médicale 2015;25(3): 200 – 203.
- Sidwell RU, Chan I, Francis N, Bunker CB: Trichophyton erinacei kerion barbae from a hedgehog with direct osculatory transfer to another person. Clin Exp Dermatol 2014; 39: 38 – 40.
Stabsarzt Tom Wilhelm
E-Mail: [email protected]
Datum: 25.12.2018

